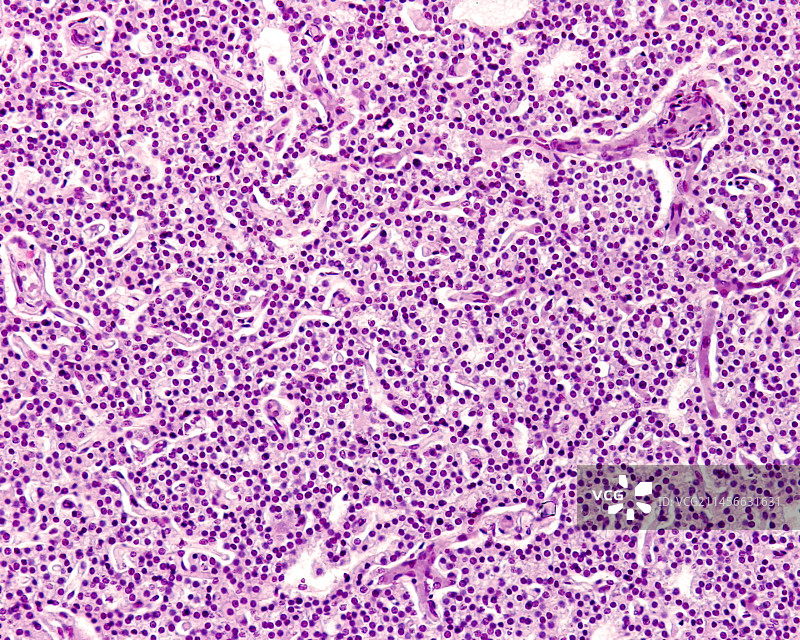

图片
- 图片
- 视频
- 音频
- 字体
儿童的甲状旁腺,光学显微照片
儿童的甲状旁腺,光学显微照片图片素材作品是由视觉中国旗下网站(VCG.COM)的图片品牌合作方:Science Photo library提供,作品作者是:JOSE CALVO / SCIENCE PHOTO LIBRARY;图片ID:VCG211456631631;最大规格:3840 x 3072 px (300ppi) | TIFF 33.75 MB;存储大小:2.87 MB - JPG;授权方式是:;当前图片素材提供下载与正版授权服务,助力您的品牌提升。
图片ID:VCG211456631631
品牌:Science Photo library
最大尺寸:3840 x 3072 px (300ppi) | TIFF 33.75 MB | 32.51 x 26.01 cm (12.80 x 10.24 in.)
存储大小:2.87 MB - JPG
购买咨询
